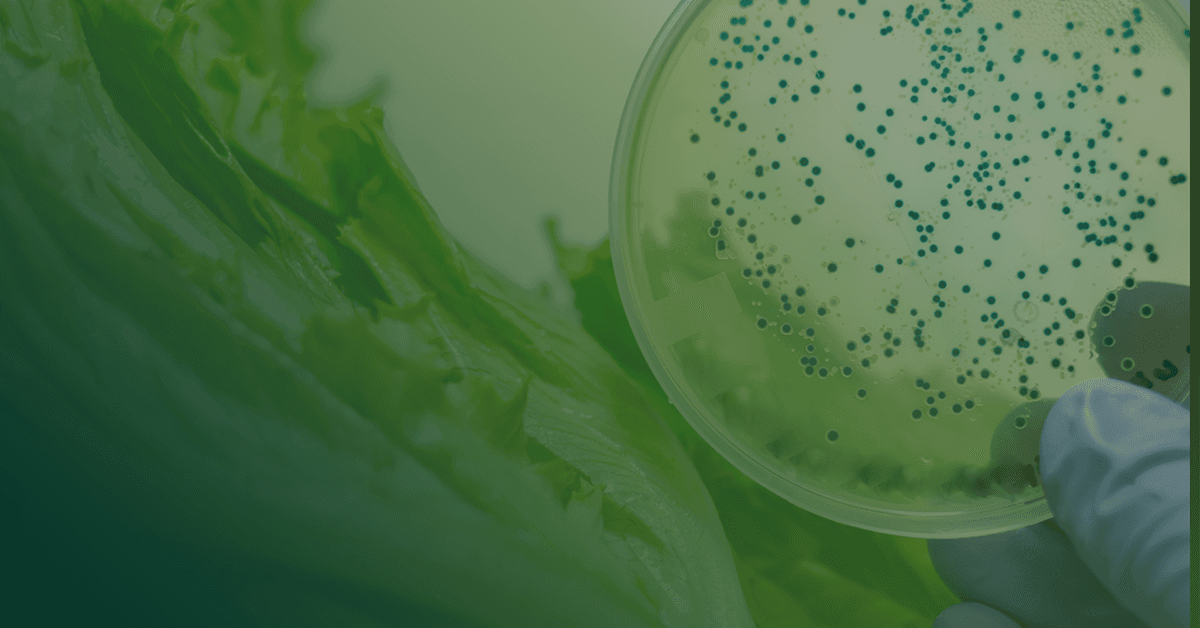

ACS Food Science & Technology will publish a Virtual Special Issue on novel approaches to detect contaminants in food. Submit your manuscript by October 15, 2023.
At this time, food security is challenging. The continuously growing world population demands more foods while maintaining their physicochemical, sensory, and microbiological quality. Increasing food production can fulfill the requirements of the world population, but this has to be synchronized with maintaining food quality during storage.
Despite all quality control processes, foods will always be exposed to toxins, pathogens, metals, viruses, and fungi, among other contaminants and residues. Thus, testing for more chemical/microbiological contaminants in food in a shorter time period has become necessary within routine laboratories and industries. Additionally, methodologies that can simultaneously check different contaminants are needed. In this sense, food packaging is relevant to protect foods from cross-contamination and to extend their shelf-life.
The development of technical devices will allow advancement of in situ methods of detection that can give an outlook of the situation in real time. This progress is needed to save time and money during the safety control of foods, with early detection of food contaminants. This Virtual Special Issue will be a platform to share this knowledge with the community and stimulate research in this field.
Submission Instructions
Manuscripts must adhere to the guidelines available on the ACS Food Science & Technology Information for Authors page and must be submitted electronically through ACS Paragon Plus.
In Paragon Plus, specify a manuscript type then select the Novel approaches to detect contaminants in food Special Issue. In addition, state in your cover letter that the paper is being submitted for the Special Issue.
All invited and contributed manuscripts will be screened for suitability upon submission and undergo the standard peer-review procedure of the journal.
The manuscript submission deadline is October 15, 2023. For more information on the journal and manuscript submission, please visit the journal webpage. Queries can be sent to Prof. Dr. Coralia Osorio Roa, Deputy Editor.
